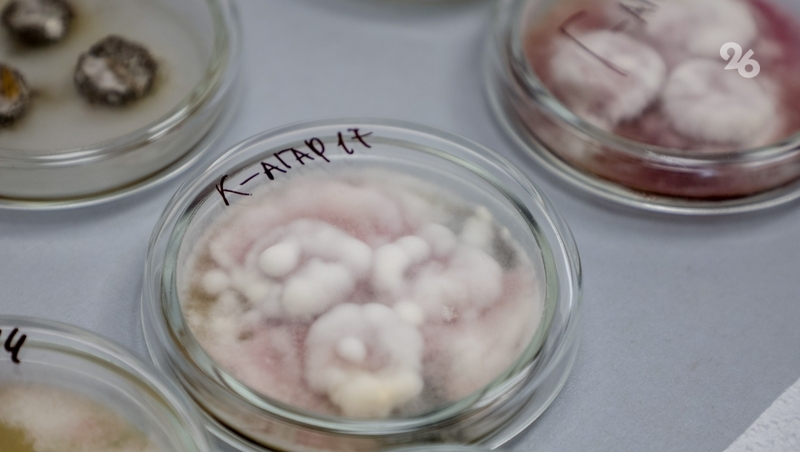

Ставрополье, как и другие регионы РФ, по поручению президента Владимира Путина должно увеличить сельхозпроизводство на 25% к 2030 году, повысить качество продукции и снизить зависимость от импорта. Губернатор региона Владимир Владимиров поставил перед аграрным сектором задачу: получить собственные семена сахарной свёклы и зерновых и наращивать показатели мясного и молочного производства. Курирует исполнение этих задач профильное министерство.


Но выполнить эти задачи, работая по старинке, не получится — на количество получаемой продукции влияет слишком много факторов: погодные условия, болезни, удорожание вспомогательных ресурсов, например, удобрений, и т. д. Поэтому в 2022 году на базе Ставропольского государственного аграрного университета решили создать институт аграрной генетики и селекции.


«Мы сейчас обязаны идти с наукой, потому что по-другому дальше не сможем двигаться. В ряде направлений в крае уже достигнут технологический «потолок», дальнейший рост возможен только через научные решения и генетику. Это направление — основное»,
— подчеркнул Ишков.


Центр ориентирован не только на фундаментальную науку, но и на практическое сопровождение агробизнеса. Здесь фермер или сельхозпредприятие могут заказать агрохимические исследования, фитопатологическую диагностику и молекулярно-генетический анализ.


Ишкову показали, как организован технологический конвейер — подготовка проб для анализа, выделение ДНК, постановка ПЦР и детекция результатов. Для больших партий используют полуавтоматическую станцию, в которой можно за 40 минут выделить ДНК сразу из 96 проб, подготовив материал для ПЦР, фрагментного анализа или секвенирования.


С помощью этих проб уже можно определять последовательность ДНК, прочитав до 1,2 тыс. нуклеотидов. И хотя это не полное секвенирование, его хватает для анализа генома растений и животных и их паспортизации — подтверждения по генетическим маркерам хозяйственно-полезных признаков для использования в селекции.


«Такое исследование помогает определить, насколько сорта и породы совместимы. И срок выведения нового сорта или породы сокращается в два–три раза, например, а для злаковых с десяти лет — до трёх–пяти. Ещё мы можем спрогнозировать, получит ли фермер при скрещивании пород запланированный результат, и будет ли потомство устойчиво к болезням и сохранению новых признаков»,
— отметила доцент кафедры защиты растений, экологии и химии, научный сотрудник лаборатории молекулярно-генетических исследований и селекции растений Ирина Ковалёва.


Далее делегация осмотрела лабораторию фитосанитарного мониторинга и диагностики. Где, в частности, исследуют сахарную свёклу на разных питательных средах — например, на картофельном или голодном агаре, чтобы выявить, каким заболеваниям тот или иной сорт подвержен.

«В условиях поставленных губернатором Владимиром Владимировым задач по импортозамещению семян сахарной свёклы для края принципиально важно понимать, какие болезни наиболее актуальны и какие сорта к ним устойчивы»,
— рассказала заведующая лабораторией фитосанитарного мониторинга и диагностики, доцент кафедры защиты растений, экологии и химии, кандидат сельскохозяйственных наук Людмила Михно.


Одно из ключевых направлений работы центра — почвенная микробиология. В лаборатории оценивают патогенный комплекс, биологическую активность и баланс, выявляют антагонистов патогенов, формируют рекомендации для хозяйств — от выбора культуры под посадку до количества вносимых удобрений.


«Задача сейчас — управление плодородием с помощью мониторинга микробиологического состояния почвы. Лаборатория выдаёт отчёт, оценивающий риски для конкретной культуры, и помогающий принять решение по севообороту и защите растений»,
— рассказала заведующая лабораторией почвенной микробиологии, доктор сельскохозяйственных наук, профессор Вера Фаизова.


Центр выполняет и ещё одну важную стратегическую задачу, поставленную губернатором Ставрополья — привлекает молодёжь к работе в аграрном секторе. Учёным центра помогают студенты.


«Мы занимаемся постановкой электрофореза, чтобы определить полезно-хозяйственные свойства сортов яблонь, которые исследуем: устойчивость к заболеваниям, а также лёжкость»,
— поделилась студентка второго курса направления «Генетика и селекция» Анна Хорошенова.


В завершение визита ректор СтГАУ Владимир Ситников добавил, что университету есть что представить и министерству, и аграриям — все разработки центра могут стать ключом к решению ряда задач, поставленных президентом и губернатором.


Ранее Владимир Владимиров сообщал, что в Ставропольском крае прогнозируют рост урожая зерновых. Этому способствуют элитные семена и передовые технологии.